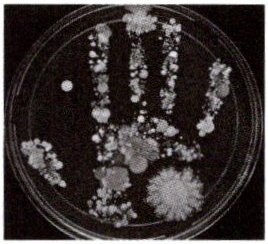

第97页
- 第1页
- 第2页
- 第3页
- 第4页
- 第5页
- 第6页
- 第7页
- 第8页
- 第9页
- 第10页
- 第11页
- 第12页
- 第13页
- 第14页
- 第15页
- 第16页
- 第17页
- 第18页
- 第19页
- 第20页
- 第21页
- 第22页
- 第23页
- 第24页
- 第25页
- 第26页
- 第27页
- 第28页
- 第29页
- 第30页
- 第31页
- 第32页
- 第33页
- 第34页
- 第35页
- 第36页
- 第37页
- 第38页
- 第39页
- 第40页
- 第41页
- 第42页
- 第43页
- 第44页
- 第45页
- 第46页
- 第47页
- 第48页
- 第49页
- 第50页
- 第51页
- 第52页
- 第53页
- 第54页
- 第55页
- 第56页
- 第57页
- 第58页
- 第59页
- 第60页
- 第61页
- 第62页
- 第63页
- 第64页
- 第65页
- 第66页
- 第67页
- 第68页
- 第69页
- 第70页
- 第71页
- 第72页
- 第73页
- 第74页
- 第75页
- 第76页
- 第77页
- 第78页
- 第79页
- 第80页
- 第81页
- 第82页
- 第83页
- 第84页
- 第85页
- 第86页
- 第87页
- 第88页
- 第89页
- 第90页
- 第91页
- 第92页
- 第93页
- 第94页
- 第95页
- 第96页
- 第97页
- 第98页
- 第99页
- 第100页
- 第101页
- 第102页
- 第103页
- 第104页
- 第105页
- 第106页
- 第107页
- 第108页
- 第109页
- 第110页
- 第111页
- 第112页
- 第113页
- 第114页
- 第115页
- 第116页
- 第117页
- 第118页
- 第119页
3. 某兴趣小组的同学将硬币放在灭菌后的固体培养基上按压片刻,培养数天后发现培养基上出现多种菌落。下列特征可作为判断菌落为细菌菌落依据的是( )
A.较大,呈白色絮状
B.较小,表面光滑黏稠
C.较大,呈褐色
D.较大,呈黑色绒毛状
A.较大,呈白色絮状
B.较小,表面光滑黏稠
C.较大,呈褐色
D.较大,呈黑色绒毛状
答案:
B
4. 为了探究霉菌生存的条件,小明进行了下图所示的实验。该实验说明霉菌的生存需要( )

A.一定的水分
B.适宜的温度
C.丰富的有机物
D.充足的氧气
A.一定的水分
B.适宜的温度
C.丰富的有机物
D.充足的氧气
答案:
A
5. 细菌不仅存在于我们周围的环境中,科学家还发现在一些极端的环境,如温泉、放射性废弃物,甚至是深海底部火山口附近也存在细菌。这一事实说明( )
A.细菌的生存不需要特定的条件
B.细菌起源于极端环境
C.所有细菌都耐高温
D.细菌分布很广泛
A.细菌的生存不需要特定的条件
B.细菌起源于极端环境
C.所有细菌都耐高温
D.细菌分布很广泛
答案:
D
6. 下列四种环境中,细菌和真菌分布最多的是( )
A.腌制食品的盐水中
B.真空的罐头食品中
C.流通的货币上
D.刚煮熟的食物上
A.腌制食品的盐水中
B.真空的罐头食品中
C.流通的货币上
D.刚煮熟的食物上
答案:
C
7. 用肥皂洗手能减少手上的细菌数量吗?某生物学兴趣小组的同学为了探究洗手前后手上细菌数量的变化,设计了如右上表所示的实验,但还不够完善。下列对该实验的四种修改方法,正确的是( )
|组别|培养皿|接种|培养温度/℃|
|甲|高温灭菌、冷却|洗手前在培养基上轻轻按一下,盖上皿盖|28|
|乙|高温灭菌、冷却|用肥皂洗手后在培养基上轻轻按一下,不盖皿盖|28|

A.甲组培养皿高温灭菌,乙组不用高温灭菌
B.甲组需要接种,乙组不需要接种
C.甲、乙两组接种后都需要盖上皿盖
D.甲、乙两组应该放置在不同温度的环境中
|组别|培养皿|接种|培养温度/℃|
|甲|高温灭菌、冷却|洗手前在培养基上轻轻按一下,盖上皿盖|28|
|乙|高温灭菌、冷却|用肥皂洗手后在培养基上轻轻按一下,不盖皿盖|28|
A.甲组培养皿高温灭菌,乙组不用高温灭菌
B.甲组需要接种,乙组不需要接种
C.甲、乙两组接种后都需要盖上皿盖
D.甲、乙两组应该放置在不同温度的环境中
答案:
C
8. 人们常说:“菌从手来,病从口入。”人的手上分布有大量微生物,无菌固体培养基经人手按压,培养一段时间后呈现如图所示的结果。下列相关叙述错误的是( )

A.培养基上生长的菌落的形态、大小不同
B.手上可能既有细菌又有真菌
C.用清水洗手可起到灭菌的作用
D.手上的微生物不一定都对人体有害
A.培养基上生长的菌落的形态、大小不同
B.手上可能既有细菌又有真菌
C.用清水洗手可起到灭菌的作用
D.手上的微生物不一定都对人体有害
答案:
C 解析:清水可以洗掉部分微生物,但不能杀死微生物,不能起到灭菌的作用。
9. 已知Ⅰ培养基含盐,Ⅱ培养基不含盐。在Ⅰ、Ⅱ培养基上都接种甲、乙两种细菌,培养几天后结果如下图所示,Ⅰ培养基上只有乙细菌的菌落,Ⅱ培养基上甲、乙两种细菌的菌落都有。下列有关推测最合理的是( )
A.Ⅰ培养基中缺少有机物
B.Ⅱ培养基中缺少水
C.乙细菌能在有盐条件下生存
D.甲细菌能在有盐条件下生存
A.Ⅰ培养基中缺少有机物
B.Ⅱ培养基中缺少水
C.乙细菌能在有盐条件下生存
D.甲细菌能在有盐条件下生存
答案:
C 解析:已知Ⅰ培养基含盐,Ⅱ培养基不含盐。在Ⅰ、Ⅱ培养基上都接种甲、乙两种细菌,培养几天后结果显示Ⅰ培养基上只有乙细菌的菌落,Ⅱ培养基上甲、乙两种细菌的菌落都有,表明乙细菌能在有盐条件下生存,而甲细菌不能在有盐条件下生存。
查看更多完整答案,请扫码查看